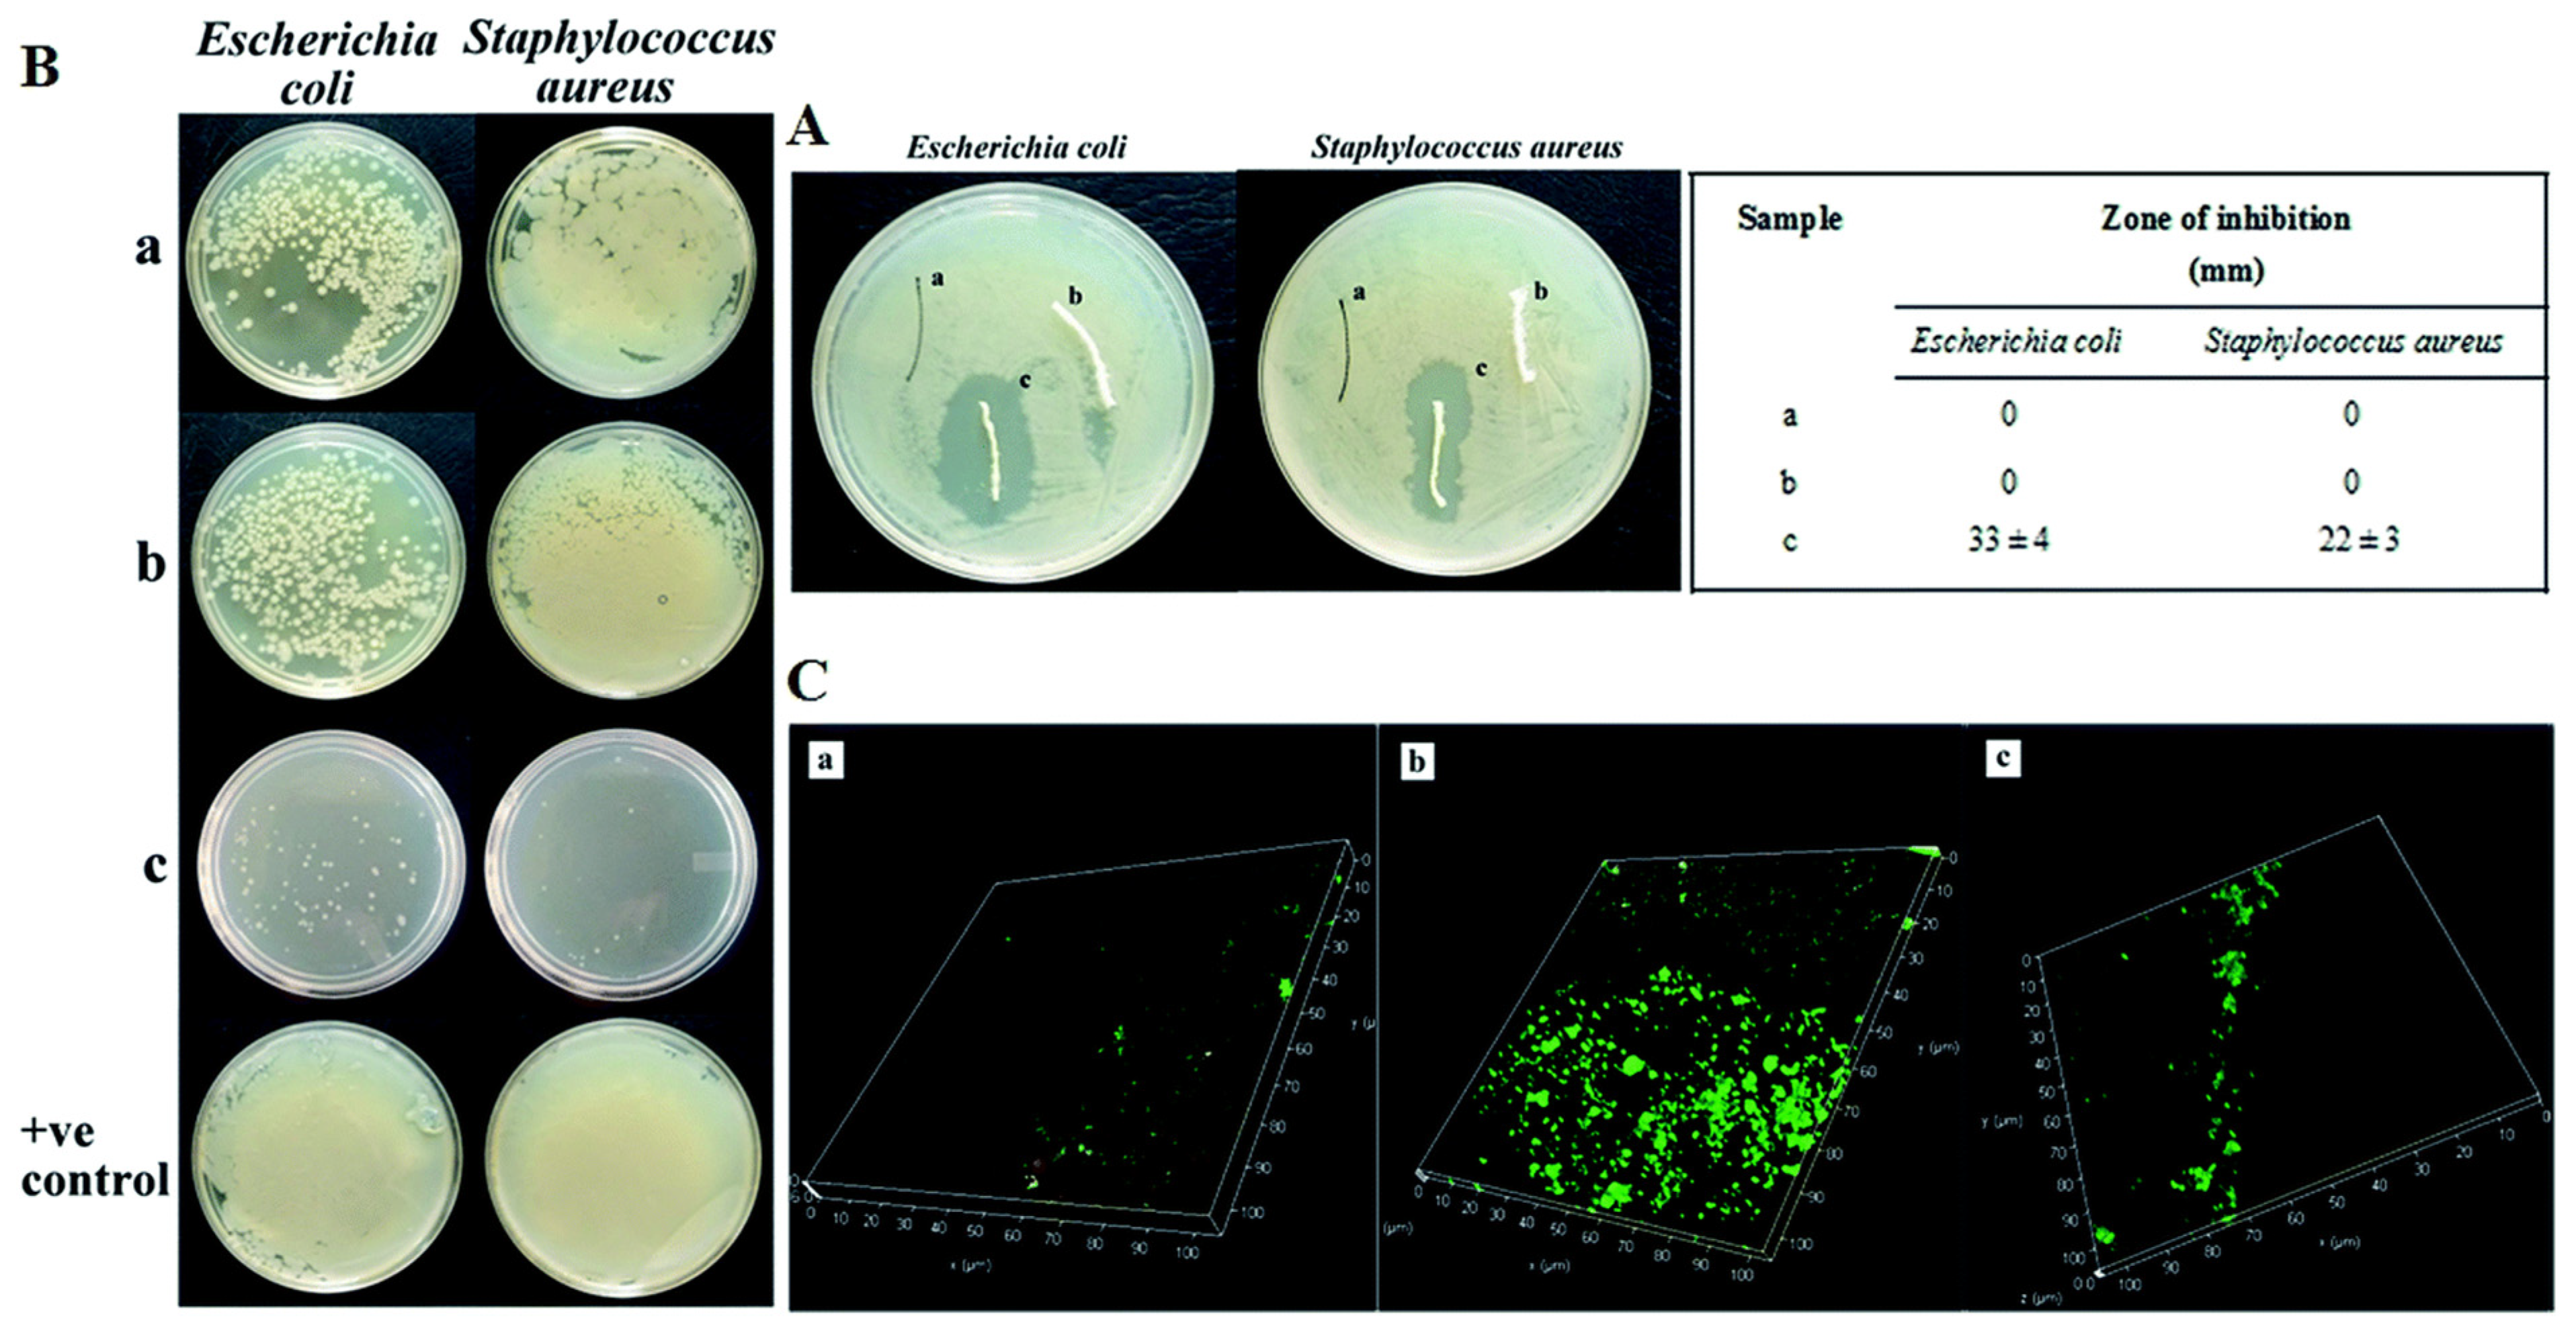
Coatings 12 00211 g005

Biopolymers for Surgical Applications
Abstract
1. Introduction
2. Biopolymers Used for Surgical Applications
2.1. Chitosan
2.2. Alginate
2.3. Hyaluronic Acid and its Derivatives
2.4. Collagen
2.5. Silk Fibroin
3. Applications of Biopolymers for Surgical Needs
3.1. Adhesives and Sealants
3.2. Sutures
3.3. Coatings
4. Conclusions and Future Perspectives
Author Contributions
Funding
Institutional Review Board Statement
Informed Consent Statement
Data Availability Statement
Conflicts of Interest
References
- Park, S.B.; Lih, E.; Park, K.S.; Joung, Y.K.; Han, D.K. Biopolymer-based functional composites for medical applications. Progr. Polym. Sci. 2017, 68, 77–105. [Google Scholar] [CrossRef]
- Mano, J.F.; Silva, G.A.; Azevedo, H.S.; Malafaya, P.B.; Souse, R.A.; Silva, S.S.; Boesel, L.F.; Oliveira, J.M.; Santos, T.C.; Marques, A.P.; et al. Natural origin biodegradable systems in tissue engineering and regenerative medicine: Present status and some moving trends. J. R. Soc. Interface 2007, 4, 999–1030. [Google Scholar] [CrossRef]
- Dhandayuthapani, B.; Yoshida, Y.; Maekawa, T.; Kumar, D.S. Polymeric scaffolds in tissue engineering application: A review. Int. J. Polym. Sci. 2011, 290602, 1–19. [Google Scholar] [CrossRef]
- Cziple, F.A.; Antonio, J.; Marques, V. Biopolymers Versus Synthetic Polymers. Anul 2008, 1, 125–132. [Google Scholar]
- Augustine, R.; Rajakumari, R.; Mozeti, M.; George, A. Biopolymers for Health, Food, and Cosmetic Applications. In Handbook of Biopolymer-Based Materials: From Blends and Composites to Gels and Complex Networks, 1st ed.; Thomas, S., Durand, D., Chassenieux, C., Jyotishkumar, P., Eds.; Wiley-VCH: Hoboken, NJ, USA, 2013; pp. 801–851. [Google Scholar]
- Niaounakis, M. Medical, Dental, and Pharmaceutical Applications. In Biopolymers: Applications and Trends; Niaounakis, M., Ed.; Elsevier: Amsterdam, The Netherlands, 2015; pp. 291–405. [Google Scholar]
- Rebelo, R.; Fernandes, M.; Fangueiro, R. Biopolymers in Medical Implants: A Brief Review. Procedia Eng. 2017, 200, 236–243. [Google Scholar] [CrossRef]
- Cheaburu Yilmaz, C.N.; Tuncay-Tanriverdi, S.; Ozer, O.; Vasile, C. Polysaccharide containing gels for pharmaceutical applications. In Polymer Gels: Science and Fundamentals, Kumar Thakur, V.K., Thakur, M.K., Eds.; Springer: Berlin/Heidelberg, Germany, 2018; pp. 231–278. [Google Scholar]
- Ciobanu, C.S.; Iconaru, S.L.; Predoi, D.; Trușcă, R.-D.; Prodan, A.M.; Groza, A.; Chifiriuc, M.C.; Beuran, M. Fabrication of Novel Chitosan–Hydroxyapatite Nanostructured Thin Films for Biomedical Applications. Coatings 2021, 11, 1561. [Google Scholar] [CrossRef]
- Akhtar, M.A.; Hadzhieva, Z.; Dlouhý, I.; Boccaccini, A.R. Electrophoretic Deposition and Characterization of Functional Coatings Based on an Antibacterial Gallium (III)-Chitosan Complex. Coatings 2020, 10, 483. [Google Scholar] [CrossRef]
- Gull, N.; Khan, S.M.; Khalid, S.; Zia, S.; Islam, A.; Sabir, A.; Sultan, M.; Hussain, F.; Khan, R.U.; Butt, M.T.Z. Designing of biocompatible and biodegradable chitosan based crosslinked hydrogel for in vitro release of encapsulated povidone-iodine: A clinical translation. Int. J. Biol. Macromol. 2020, 164, 4370–4380. [Google Scholar] [CrossRef]
- Gull, N.; Khan, S.M.; Butt, O.M.; Islam, A.; Shah, A.; Jabeen, S.; Khan, S.U.; Khan, A.; Khan, R.U.; Butt, M.T.Z. Inflammation targeted chitosan-based hydrogel for controlled release of diclofenac sodium. J. Biol. Macromol. 2020, 162, 175–187. [Google Scholar] [CrossRef]
- Feng, P.; Luo, Y.; Ke, C.; Qiu, H.; Wang, W.; Zhu, Y.; Hou, R.; Xu, L.; Wu, S. Chitosan-Based Functional Materials for Skin Wound Repair: Mechanisms and Applications. Front. Bioeng. Biotechnol. 2021, 9, 650598. [Google Scholar] [CrossRef]
- Cheaburu Yilmaz, C.N.; Vasile, C.; Ciocoiu, O.N.; Staikos, G. Sodium alginate grafted with poly(N-isopropylacrylamide). In Temperature-Responsive Polymers: Chemistry, Properties, and Applications; Khutoryanskiy, V.V., Georgiou, T.K., Eds.; Wiley: Hoboken, NJ, USA, 2018; p. 408. [Google Scholar]
- Barbu, A.; Neamtu, B.; Zahan, M.; Iancu, G.M.; Bacila, C.; Miresan, V. Current Trends in Advanced Alginate-Based Wound Dressings for Chronic Wounds. J. Pers. Med. 2021, 11, 890. [Google Scholar] [CrossRef] [PubMed]
- Cheaburu Yilmaz, C.N.; Pamfil, D.; Vasile, C.; Bibire, N.; Lupuşoru, R.V.; Zamfir, C.L.; Lupușoru, C.E. Toxicity, Biocompatibil-ity, pH-Responsiveness and Methotrexate Release from PVA/Hyaluronic Acid Cryogels for Psoriasis Therapy. Polymers 2017, 9, 123. [Google Scholar] [CrossRef] [PubMed]
- Tuncay-Tanriverdi, S.; Cheaburu Yilmaz, C.N.; Carbone, S.; Özer, O. Preparation and In-vitro Evaluation of Melatonin Loaded HA/PVA Gel Formulations. Pharm. Dev. Technol. 2018, 23, 815–825. [Google Scholar] [CrossRef] [PubMed]
- Graça, M.F.P.; Miguel, S.P.; Cabral, C.S.D.; Correia, I.J. Hyaluronic acid—Based wound dressings: A review. Carbohydr. Polym. 2020, 241, 116364. [Google Scholar] [CrossRef]
- Goldberga, I.; Li, R.; Duer, M.J. Collagen Structure–Function Relationships from Solid-State NMR Spectroscopy. Acc. Chem. Res. 2018, 51, 1621–1629. [Google Scholar] [CrossRef]
- Mathew-Steiner, S.S.; Roy, S.; Sen, C.K. Collagen in Wound Healing. Bioengineering 2021, 8, 63. [Google Scholar] [CrossRef] [PubMed]
- Asakura, T. Structure of Silk I (Bombyx mori Silk Fibroin before Spinning) -Type II β-Turn, not α-Helix-. Molecules 2021, 26, 3706. [Google Scholar] [CrossRef]
- Tanaka, T.; Abe, Y.; Cheng, C.J.; Tanaka, R.; Naito, A.; Asakura, T. Development of Small-Diameter Elastin-Silk Fibroin Vascular Grafts. Front. Bioeng. Biotechnol. 2021, 8, 622220. [Google Scholar] [CrossRef]
- Pollini, M.; Paladini, F. Bioinspired Materials for Wound Healing, Application: The Potential of Silk Fibroin. Materials 2020, 13, 3361. [Google Scholar] [CrossRef]
- Li, Z.; Song, J.; Zhang, J.; Hao, K.; Liu, L.; Wu, B.; Zheng, X.; Xiao, B.; Tong, X.; Dai, F. Topical application of silk fibroin-based hydrogel in preventing hypertrophic scars. Colloids Surf. B Biointerfaces 2019, 186, 110735. [Google Scholar] [CrossRef]
- Han, H.; Ning, H.; Liu, S.; Lu, Q.; Fan, Z.; Lu, H.; Lu, G.; Kaplan, D.L. Silk Biomaterials with Vascularization Capacity. Adv. Funct. Mater. 2016, 26, 421–436. [Google Scholar] [CrossRef] [PubMed]
- Cherng, J.H.; Chou, S.C.; Chen, C.L.; Wang, Y.W.; Chang, S.J.; Fan, G.Y.; Leung, F.S.; Meng, E. Bacterial Cellulose as a Potential Bio-Scaffold for Effective Re-Epithelialization Therapy. Pharmaceutics 2021, 13, 1592. [Google Scholar] [CrossRef] [PubMed]
- El Masry, M.S.; Chaffee, S.; Das Ghatak, P.; Mathew-Steiner, S.S.; Das, A.; Higuita-Castro, N.; Roy, S.; Anani, R.A.; Sen, C.K. Stabilized collagen matrix dressing improves wound macrophage function and epithelialization. FASEB J. 2019, 33, 2144–2155. [Google Scholar] [CrossRef]
- SAlehi, M.; Ehterami, A.; Farzamfar, S.; Vaez, A.; Ebrahimi-Barough, S. Accelerating healing of excisional wound with alginate hydrogel containing naringenin in rat model. Drug Deliv. Transl. Res. 2021, 11, 142–153. [Google Scholar] [CrossRef] [PubMed]
- Zhou, L.; Dai, C.; Fan, L.; Jiang, Y.; Liu, C.; Zhou, Z.; Guan, P.; Tian, Y.; Xing, J.; Li, X.; et al. Injectable Self-Healing Natural Biopolymer-Based Hydrogel Adhesive with Thermoresponsive Reversible Adhesion for Minimally Invasive Surgery. Adv. Funct. Mater. 2021, 31, 2007457. [Google Scholar] [CrossRef]
- Chen, W.; Abraham, J.M. Biopolymer System for Tissue Sealing. U.S. Patent 7,854,923 B2, 21 December 2010. [Google Scholar]
- Shen, Y.; Xu, G.; Huang, H.; Wang, K.; Wang, H.; Lang, M.; Gao, H.; Zhao, S. Sequential Release of Small Extracellular Vesicles from Bilayered Thiolated Alginate/Polyethylene Glycol Diacrylate Hydrogels for Scarless Wound Healing. ACS Nano 2021, 15, 6352–6368. [Google Scholar] [CrossRef]
- Balavigneswaran, C.K.; Muthuvijayan, V. Nanohybrid-Reinforced Gelatin-Ureidopyrimidinone-Based Self-healing Injectable Hydrogels for Tissue Engineering Applications. ACS Appl. Bio Mater. 2021, 4, 5362–5377. [Google Scholar] [CrossRef]
- Qiu, X.; Zhang, J.; Cao, L.; Jiao, Q.; Zhou, J.; Yang, L.; Zhang, H.; Wei, Y. Antifouling Antioxidant Zwitterionic Dextran Hydrogels as Wound Dressing Materials with Excellent Healing Activities. ACS Appl. Mater. Interfaces 2021, 13, 7060–7069. [Google Scholar] [CrossRef]
- Deng, P.; Chen, F.; Zhang, H.; Chen, Y.; Zhou, J. Conductive, Self-Healing, Adhesive, and Antibacterial Hydrogels Based on Lignin/Cellulose for Rapid MRSA-Infected Wound Repairing. ACS Appl. Mater. Interfaces 2021, 13, 52333–52345. [Google Scholar] [CrossRef]
- Tamer, T.M.; Collins, M.N.; Valachová, K.; Hassan, M.A.; Omer, A.M.; Mohy-Eldin, M.S.; Švík, K.; Jurčík, R.; Ondruška, Ľ.; Biró, C.; et al. MitoQ Loaded Chitosan-Hyaluronan Composite Membranes for Wound Healing. Materials 2018, 11, 569. [Google Scholar] [CrossRef]
- Mizuta, R.; Taguchi, T. Hemostatic properties of in situ gels composed of hydrophobically modified biopolymers. J. Biomater. Appl. 2018, 33, 315–323. [Google Scholar] [CrossRef] [PubMed]
- Joo, G.; Sultana, T.; Rahaman, S.; Bae, S.H.; Jung, H.I.; Lee, B.T. Polycaprolactone-gelatin membrane as a sealant biomaterial efficiently prevents postoperative anastomotic leakage with promoting tissue repair. J. Biomater. Sci. Polym. Ed. 2021, 32, 1530–1547. [Google Scholar] [CrossRef] [PubMed]
- Bai, S.; Zhang, X.; Cai, P.; Huang, X.; Huang, Y.; Liu, R.; Zhang, M.; Song, J.; Chen, X.; Yang, H. A silk-based sealant with tough adhesion for instant hemostasis of bleeding tissues. Nanoscale Horiz. 2019, 4, 1333–1341. [Google Scholar] [CrossRef]
- Ghobril, C.; Grinstaff, M.W. The chemistry and engineering of polymeric hydrogel adhesives for wound closure: A tutorial. Chem. Soc. Rev. 2015, 44, 1820. [Google Scholar] [CrossRef]
- Annabi, N.; Yue, K.; Tamayol, A.; Khademhosseini, A. Elastic sealants for surgical applications. Eur. J. Pharm. Biopharm. 2015, 95, 27–39. [Google Scholar] [CrossRef]
- Meddahi-Pelle, A.; Legrand, A.; Marcellan, A.; Louedec, L.; Letourneur, D.; Leibler, L. Organ Repair, Hemostasis, and In Vivo Bonding of Medical Devices by Aqueous Solutions of Nanoparticles. Angew. Chem. Int. Ed. 2014, 53, 6369–6373. [Google Scholar] [CrossRef]
- Lang, N.; Pereira, M.J.; Lee, Y.; Friehs, I.; Vasilyev, N.V.; Feins, E.N.; Ablasser, K.; O’Cearbhaill, E.D.; Xu, C.; Fabozzo, A.; et al. A blood-resistant surgical glue for minimally invasive repair of vessels and heart defects. Sci. Transl. Med. 2014, 6, 218ra6. [Google Scholar] [CrossRef]
- Behrens, A.M.; Lee, N.G.; Casey, B.J.; Srinivasan, P.; Sikorski, M.J.; Daristotle, J.L.; Sandler, A.D.; Kofinas, P. Biodegradable-Polymer-Blend-Based Surgical Sealant with Body-Temperature-Mediated Adhesion. Adv. Mater. 2015, 27, 8056–8061. [Google Scholar] [CrossRef]
- Li, J.; Celiz, A.D.; Yang, J.; Yang, Q.; Wamala, I.; Whyte, W.; Seo, B.R.; Vasilyev, N.V.; Vlassak, J.J.; Suo, Z.; et al. Tough adhesives for diverse wet surfaces. Science 2017, 357, 378–381. [Google Scholar] [CrossRef]
- Gasek, N.; Park, H.E.; Uriarte, J.J.; Uhl, F.E.; Pouliot, R.A.; Riveron, A.; Moss, T.; Phillips, Z.; Louie, J.; Sharma, I.; et al. Development of alginate and gelatin-based pleural and tracheal sealants. Acta Biomater. 2021, 131, 222–235. [Google Scholar] [CrossRef]
- Lilly, J.L.; Gottipati, A.; Cahall, C.F.; Agoub, M.; Berron, B.J. Comparison of eosin and fluorescein conjugates for the photoinitiation of cell-compatible polymer coatings. PLoS ONE 2018, 13, e0190880. [Google Scholar] [CrossRef] [PubMed]
- Wei, Q.; Zhang, Z.; Li, J.; Li, B.; Zhao, C. Oxidant-induced dopamine polymerization for multifunctional coatings. Polym. Chem. 2010, 1, 1430–1433. [Google Scholar] [CrossRef]
- Scognamiglio, F.; Travan, A.; Borgogna, M.; Donati, I.; Marsich, E.; Bosmans, J.W.A.M.; Perge, L.; Foulc, M.P.; Bouvy, N.D.; Paoletti, S. Enhanced bioadhesivity of dopamine-functionalized polysaccharidic membranes for general surgery applications. Acta Biomater. 2016, 44, 232–242. [Google Scholar] [CrossRef]
- Qin, Z.; Buehler, M.J. Molecular mechanics of mussel adhesion proteins. J. Mech. Phys. Solid. 2014, 62, 19–30. [Google Scholar] [CrossRef]
- Ma, H.; Luo, J.; Sun, Z.; Xia, L.; Shi, M.; Liu, M.; Chang, J.; Wu, C. 3D printing of biomaterials with mussel-inspired nanostructures for tumor therapy and tissue regeneration. Biomaterials 2016, 111, 138–148. [Google Scholar] [CrossRef]
- Rajabi, N.; Kharaziha, M.; Emadi, R.; Zarrabi, A.; Mokhtari, H.; Salehi, S. An adhesive and injectable nanocomposite hydrogel of thiolated gelatin/gelatin methacrylate/Laponite® as a potential surgical sealant. J. Colloid Interface Sci. 2019, 564, 155–169. [Google Scholar] [CrossRef]
- Tiwari, S.; Pratyush, D.D.; Gupta, S.K.; Singh, S.K. Significance of Surgical Intervention in the Management of Diabetic Foot Infections. In Microbiology for Surgical Infections Diagnosis, Prognosis and Treatment; Kon, K., Rai, M., Eds.; Elsevier: Amsterdam, The Netherlands, 2014; pp. 251–266. [Google Scholar]
- Gorgieva, S.; Zemljić, L.F.; Strnad, S.; Kokol, V. Textile-based biomaterials for surgical applications. In Fundamental Biomaterials: Polymers; Thomas, S., Balakrishnan, P., Sreekala, M.S., Eds.; Elsevier: Amsterdam, The Netherlands, 2018; pp. 179–215. [Google Scholar]
- Kümmerle, J.M. Suture materials and patterns. In Equine Surgery, 4th ed.; Auer, J., Stick, J., Eds.; Elsevier: Amsterdam, The Netherlands, 2012; pp. 255–280. [Google Scholar]
- Sanz, L.E. Selecting the best suture material. Contemp. OB/GYN 2001, 46, 57–72. [Google Scholar]
- Sharma, A.; Mehrotra, S. Is Catgut Really Obsolete? Experience with Buried Subcuticular Catgut Sutures in Operative Wounds. Med. J. Armed. Forces India 2002, 58, 217–220. [Google Scholar] [CrossRef][Green Version]
- Shubha, P.; Gowda, M.; Namratha, K.; Shyamsunder, S.; Manjunatha, H.B.; Byrappa, K. Ex-situ fabrication of ZnO nanoparticles coated silk fiber for surgical applications. Mater. Chem. Phys. 2019, 49, 21–26. [Google Scholar] [CrossRef]
- Franco, A.R.; Fernandes, E.M.; Rodrigues, M.T.; Rodrigues, F.J.; Gomes, M.E.; Leonor, I.B.; Kaplan, D.L.; Reis, R.L. Antimicrobial coating of spider silk to prevent bacterial attachment on silk surgical sutures. Acta Biomater. 2019, 99, 236–246. [Google Scholar] [CrossRef]
- Kalita, H.; Hazarika, A.; Kalita, S.; Kandimalla, R.; Devi, R. Antimicrobials tethering on suture surface through a hydrogel: A novel strategy to combat postoperative wound infections. RSC Adv. 2017, 7, 32637–33246. [Google Scholar] [CrossRef]
- Deng, X.; Gould, M.; Ali, M.A. Fabrication and characterisation of melt-extruded chitosan/keratin/PCL/PEG drug-eluting sutures designed for wound healing. Mater. Sci. Eng. C 2021, 120, 111696. [Google Scholar] [CrossRef]
- Kashiwabuchi, F.; Parikh, K.S.; Omiadze, R.; Zhang, S.; Luo, L.; Patel, H.V.; Xu, Q.; Ensign, L.M.; Mao, H.Q.; Hanes, J.; et al. Development of Absorbable, Antibiotic-Eluting Sutures for Ophthalmic Surgery. Transl. Vis. Sci. Technol. 2017, 6, 1. [Google Scholar] [PubMed]
- Chen, X.; Hou, D.; Wang, L.; Zhang, Q.; Zou, J.; Sun, G. Antibacterial Surgical Silk Sutures Using a High-Performance Slow-Release Carrier Coating System. ACS Appl. Mater. Interfaces 2015, 7, 22394–22403. [Google Scholar] [CrossRef]
- Kim, H.; Kim, B.H.; Huh, B.K.; Yoo, Y.C.; Heo, C.Y.; Choy, Y.B.; Park, J.H. Surgical suture releasing macrophage-targeted drug-loaded nanoparticles for an enhanced anti-inflammatory effect. Biomater. Sci. 2017, 5, 1670–1677. [Google Scholar] [CrossRef] [PubMed]
- Mahantesha, S.; Ashwini, S.; Manjusha, M.V.; Ramya, G.; Shivani, S.R.D. Comparative Evaluation of the Efficacy of Surgical Suture Coated with Analgesic versus Conventional Suture for Sustained Local Pain Relief- Pilot Study. J. Chem. Pharm. Rese. 2018, 10, 13–21. [Google Scholar]
- Richard, A.S.; Verma, R.S. Bioactive nano yarns as surgical sutures for wound healing. Mater. Sci. Eng. C 2021, 128, 112334. [Google Scholar] [CrossRef]
- Zhou, Y.L.; Yang, Q.Q.; Zhang, L.; Tang, J.B. Nanoparticle-coated sutures providing sustained growth factor delivery to improve the healing strength of injured tendons. Acta Biomater. 2021, 124, 301–314. [Google Scholar] [CrossRef]
- Zhang, Q.; Qiao, Y.; Zhu, J.; Li, Y.; Li, C.; Lin, J.; Li, X.; Han, H.; Mao, J.; Wang, F.; et al. Electroactive and antibacterial surgical sutures based on chitosan-gelatin/tannic acid/polypyrrole composite coating. Compos. B Eng. 2021, 223, 109140. [Google Scholar] [CrossRef]
- Sneha, K.R.; Steny, P.S.; Sailaja, G.S. Intrinsically radiopaque and antimicrobial cellulose based surgical sutures from mechanically powerful Agave sisalana plant leaf fibers. Biomater. Sci. 2021, 9, 7944–7961. [Google Scholar] [CrossRef]
- Tan, G.; Xu, J.; Chirume, W.M.; Zhang, J.; Zhang, H.; Hu, X. Antibacterial and Anti-Inflammatory Coating Materials for Orthopedic Implants: A Review. Coatings 2021, 11, 1401. [Google Scholar] [CrossRef]
- Gradinaru, I.; Timofte, D.; Vasincu, D.; Telsoianu, D.; Cimpoesu, R.; Manole, V.; Gheuca-Solovastru, L. Preliminary Results on Pulsed Laser Deposition of PMMA on Nitinol Substrate. Mater. Plast. 2014, 51, 230–234. [Google Scholar]
- Yilmaz, O.; Yorgancioglu, A. Nanocoatings: Preparation, Properties, and Biomedical Applications, In Micro and Nano Technologies, Polymeric Nanomaterials in Nanotherapeutics, 1st ed.; Vasile, C., Ed.; Elsevier: Amsterdam, The Netherlands, 2019; pp. 299–331. [Google Scholar]
- Aydemir, T.; Liverani, L.; Pastore, J.I.; Ceré, S.M.; Goldmann, W.H.; Boccaccini, A.R.; Ballarre, J. Functional behavior of chitosan/gelatin/silica-gentamicin coatings by electrophoretic deposition on surgical grade stainless steel. Mater. Sci. Eng. C 2020, 115, 111062. [Google Scholar] [CrossRef] [PubMed]
- Mebert, A.M.; Aimé, C.; Alvarez, G.S.; Shi, Y.; Flor, S.A.; Lucangioli, S.E.; Desimone, M.F.; Coradin, T. Silica core–shell particles for the dual delivery of gentamicin and rifamycin antibiotics. J. Mater. Chem. B 2016, 4, 3135–3144. [Google Scholar] [CrossRef]
- Perkins, J.; Hong, Y.; Ye, S.H.; Wagner, W.R.; Desai, S. Direct writing of bio-functional coatings for cardiovascular applications. J. Biomed. Mater. Res. Part A 2014, 102, 4290–4300. [Google Scholar] [CrossRef]
- Gawad, S.A.; Nasr, A.; Fekry, A.M.; Filippov, L.O. Electrochemical and hydrogen evolution behaviour of a novel nano-cobalt/nano-chitosan composite coating on a surgical 316L stainless steel alloy as an implant. Int. J. Hydrog. Energy 2021, 46, 18233–18241. [Google Scholar] [CrossRef]
- Muro-Fraguas, I.; Sainz-García, A.; López, M.; Rojo-Bezares, B.; Múgica-Vidal, R.; Sainz-García, E.; Toledano, P.; Sáenz, Y.; González-Marcos, A.; Alba-Elías, F. Antibiofilm coatings through atmospheric pressure plasma for 3D printed surgical instruments. Surf. Coat. Technol. 2020, 399, 126163. [Google Scholar] [CrossRef]
- Marinaro, F.; Sánchez-Margallo, F.M.; Álvarez, V.; López, E.; Tarazona, R.; Brun, M.V.; Blázquez, R.; Casado, J.G. Meshes in a Mess: Mesenchymal Stem Cell-Based Therapies for Soft Tissue Reinforcement. Acta Biomater. 2019, 85, 60–74. [Google Scholar] [CrossRef]
- Houshyar, S.; Sarker, A.; Jadhav, A.; Kumar, G.S.; Bhattacharyya, A.; Nayak, R.; Shanks, R.A.; Saha, T.; Rifai, A.; Padhye, R.; et al. Polypropylene-Nanodiamond Composite for Hernia Mesh. Mater. Sci. Eng. C Mater. Biol. Appl. 2020, 111, 110780. [Google Scholar] [CrossRef]
- Houshyar, S.; Mirzadeh, N.; Pillai, M.M.; Saha, T.; Khalid, A.; Bhattacharyya, A.; Dekiwadia, C.; Zizhou, R.; Cryle, M.J.; Payne, J.A.E.; et al. Surgical mesh coatings for infection control and temperature sensing: An in-vitro investigation. OpenNano 2021, 5, 100032. [Google Scholar] [CrossRef]
- Marinaro, F.; Silva, J.M.; Barros, A.A.; Aroso, I.M.; Gómez-Blanco, J.C.; Jardin, I.; Lopez, J.J.; Pulido, M.; de Pedro, M.A.; Reis, R.L.; et al. A Fibrin Coating Method of Polypropylene Meshes Enables the Adhesion of Menstrual Blood-Derived Mesenchymal Stromal Cells: A New Delivery Strategy for Stem Cell-Based Therapies. Int. J. Mol. Sci. 2021, 22, 13385. [Google Scholar] [CrossRef] [PubMed]

| Material | Composition | Preparation Method | Properties | Reference |
|---|---|---|---|---|
| Bacterial cellulose (BC) | - | Hestrin–Schramm method | Epithelial regeneration and wound healing, skin injuring material | [26] |
| Equine pericardial collagen matrix (sPCM) | - | - | Dressing for wound closure Rapid re-epithelialization and early closure | [27] |
| Alginate | Hydrogel with various concentrations of naringenin | Solutions mixing followed by freeze thaw and lyophilization | Treat full-thickness excisional wound in rats | [28] |
| Gelatin (Gel) /Chondroitin sulfate (CS) | Gel/CS | Self-crosslinking of periodate oxidized CS and Gel with borax | Surgical adhesive for sealing or reconnecting ruptured tissues | [29] |
| Chitosan/PEG and Hyaluronic acid | Alkylated chitosan or gelatin | Solution mixing, pH and temperature varied followed by gelation | Adhesive to dermal wounds | [30] |
| Bilayered thiolated alginate /PEG diacrylate | - | Thiol−ene click chemistry | Scar-free wound healing bandages and pathogenic treatment of scars | [31] |
| Alginate /ureidopyrimidinone-functionalized gelatin | Oxidized Alginate/ nanocomposite of Poly(ethylene glycol) (PEG)-poly(urethane) (PU) with cloisite | Oxidation of algitate with peiodateAddition polymerization PEG and hexamethylene diisocyanate | Self-healing hydrogels | [32] |
| Dextran based hydrogels | Zwitterionic dextran-based hydrogels using carboxybetaine dextran (CB-Dex) and sulfobetaine dextran (SB-Dex) | Michal addition of the sulfobetaine dextrane and crosslinking with methylenebisacrylamide (MBA) with various compositions | Multifunctional polysaccharide hydrogels for wound treatment and pain relief when changing wound dressings | [33] |
| Lignin/Cellulosehydrogels | Ag NPs reduced by lignin in situ combined with phenylboric acid-modified hydroxypropyl cellulose (PAHC) | Esterification of HPC in the presence of DCC DMAP: 4-carboxyphenylboronic acid- 1:10:1 (molar ratio) | Accelerate epithelial tissue regeneration, reduce inflammatory cell infiltration, promote collagen deposition, accelerate neovascularization | [34] |
| Chitosan (Ch)/High-molar-mass hyaluronan (HA) membranes | Ch:HA-1:10 wt.% Mitochondrially-targeted antioxidant—MitoQ incorporated within the CS/HA membranes | Solution mixing and solvent casting | Healing effects and initiation of homeostasis in organism | [35] |
| Hyaluronic Acid/ formaldehyde/hydrobobic groups (Dodecylamine (C12) or sterylamine (C18)) | HyA/Ald (89/11 wt%) C12-HyA (11/89 wt%) C18-HyA (11/89 wt%) | 2-picoline borane-hydrophobic modification reduce amination | Haemostatic activity | [36] |
| Porous and fibrous polycaprolactone-gelatin membranes | Membranes with different mixing ratios of PCL to gelatin (1:1, 1:2, 1:3, and 1:4) | Electro spinning technique | Prevent suture-line disruption, leakage, and promote healing of the wounded sites | [37] |
Publisher’s Note: MDPI stays neutral with regard to jurisdictional claims in published maps and institutional affiliations. |
© 2022 by the authors. Licensee MDPI, Basel, Switzerland. This article is an open access article distributed under the terms and conditions of the Creative Commons Attribution (CC BY) license (https://creativecommons.org/licenses/by/4.0/).
Share and Cite
Bibire, T.; Yilmaz, O.; Ghiciuc, C.M.; Bibire, N.; Dănilă, R. Biopolymers for Surgical Applications. Coatings 2022, 12, 211. https://doi.org/10.3390/coatings12020211
Bibire T, Yilmaz O, Ghiciuc CM, Bibire N, Dănilă R. Biopolymers for Surgical Applications. Coatings. 2022; 12(2):211. https://doi.org/10.3390/coatings12020211
Chicago/Turabian StyleBibire, Tudor, Onur Yilmaz, Cristina Mihaela Ghiciuc, Nela Bibire, and Radu Dănilă. 2022. "Biopolymers for Surgical Applications" Coatings 12, no. 2: 211. https://doi.org/10.3390/coatings12020211
APA StyleBibire, T., Yilmaz, O., Ghiciuc, C. M., Bibire, N., & Dănilă, R. (2022). Biopolymers for Surgical Applications. Coatings, 12(2), 211. https://doi.org/10.3390/coatings12020211

